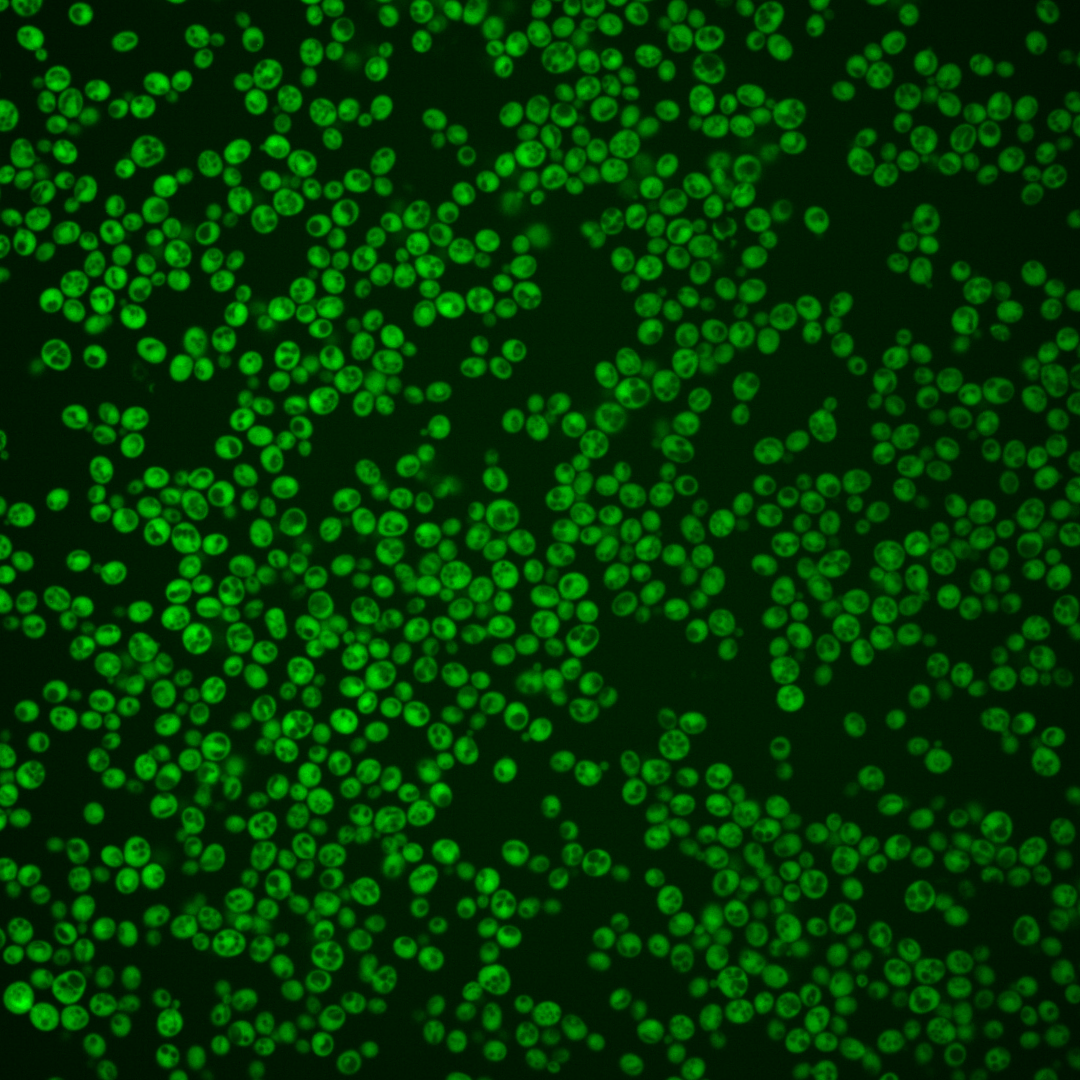
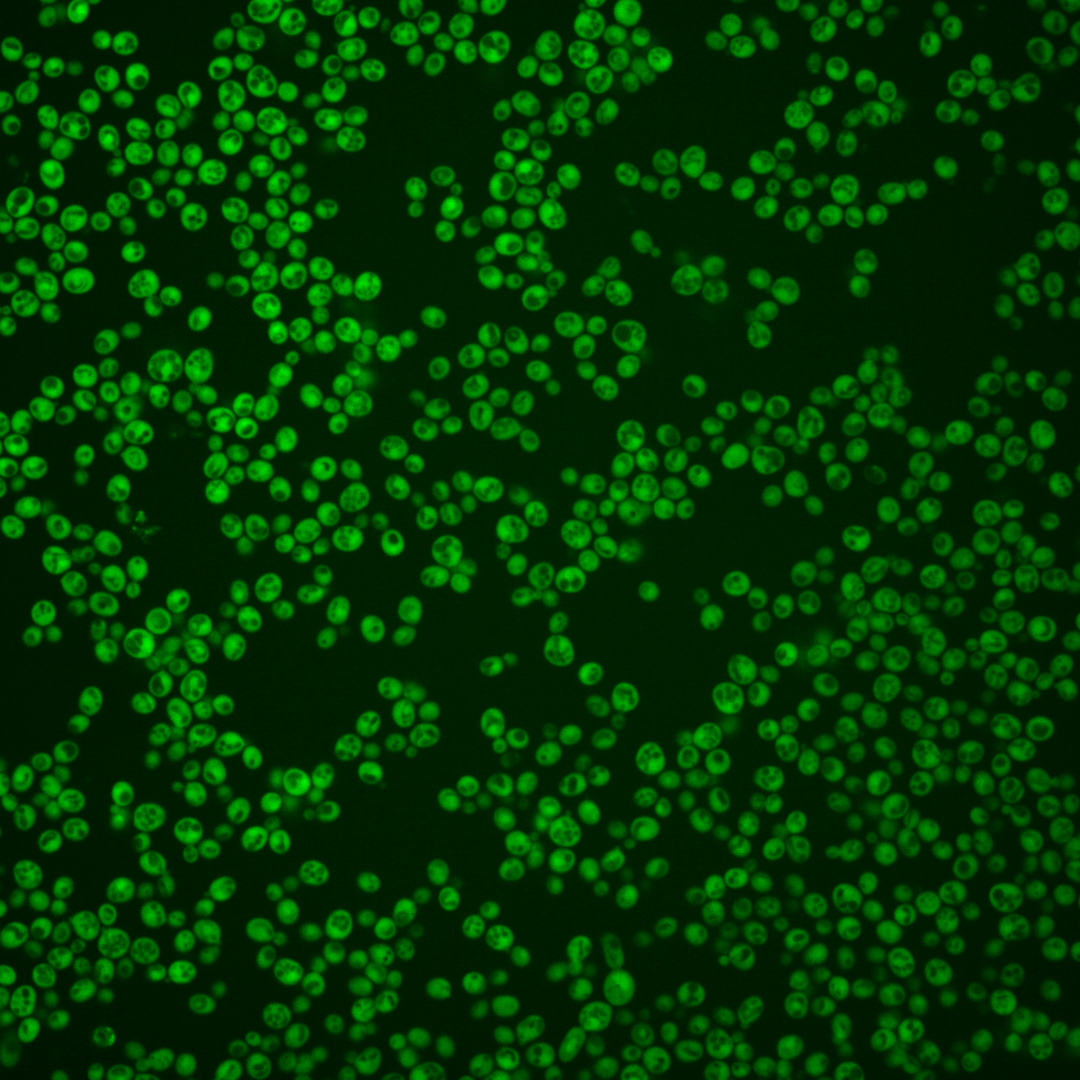
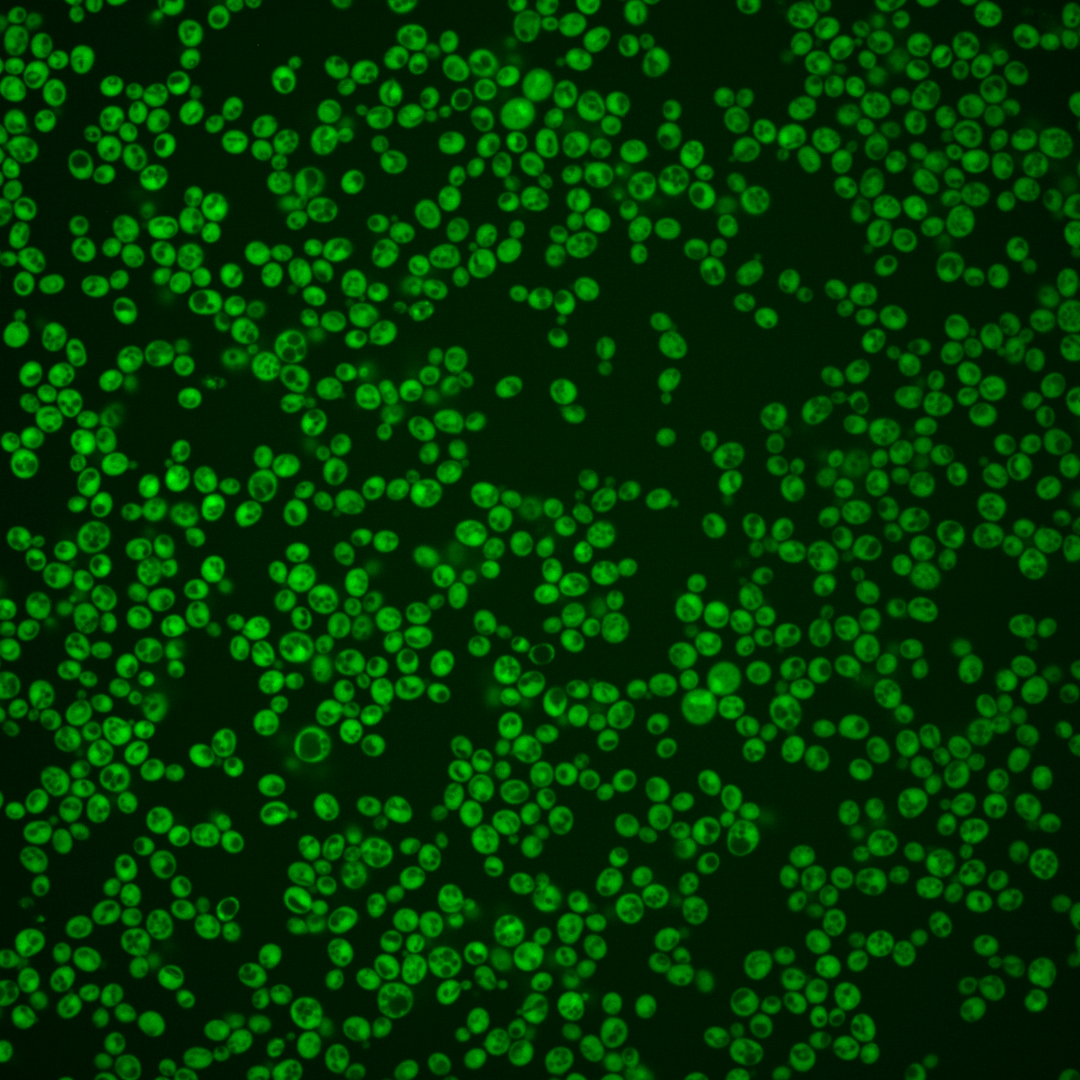
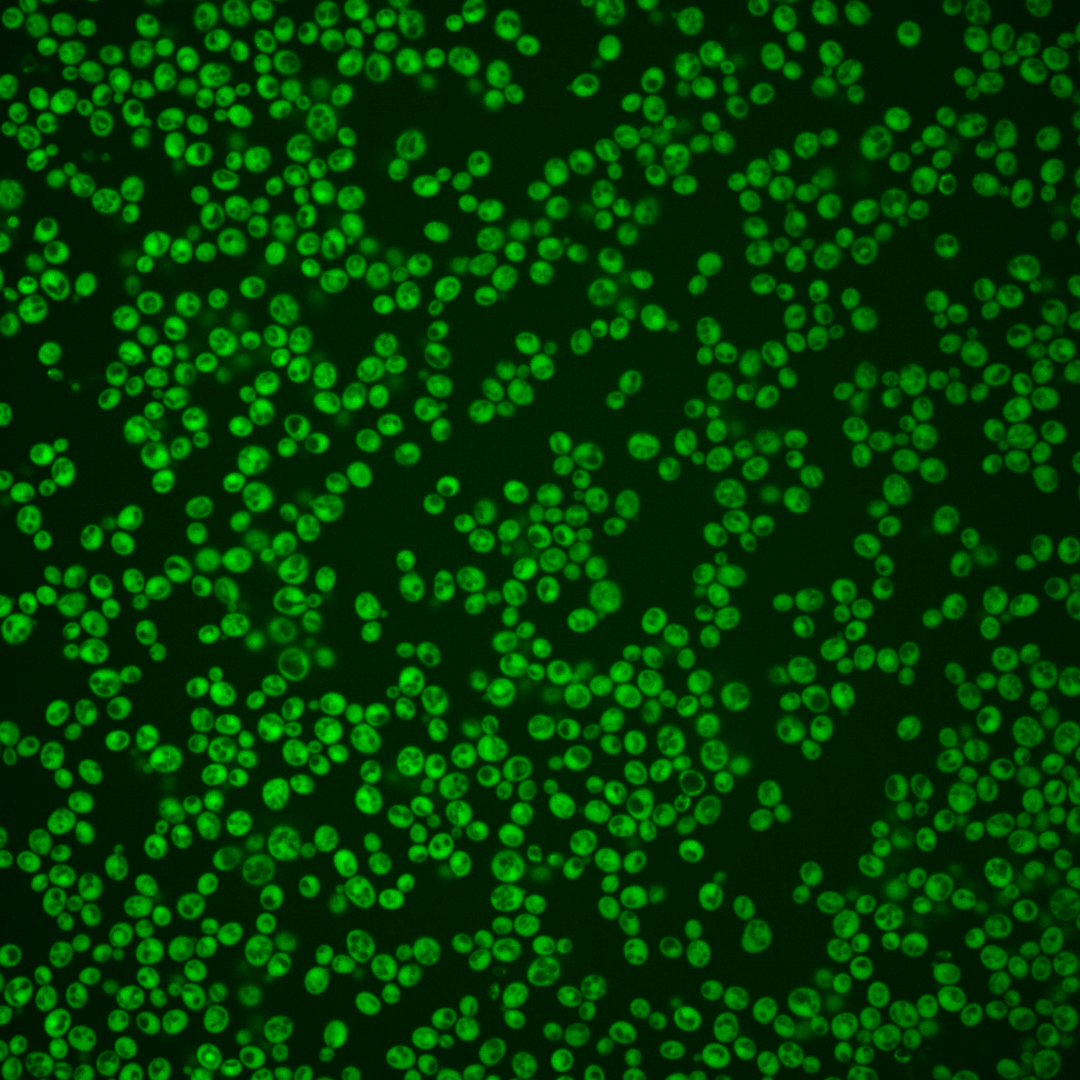
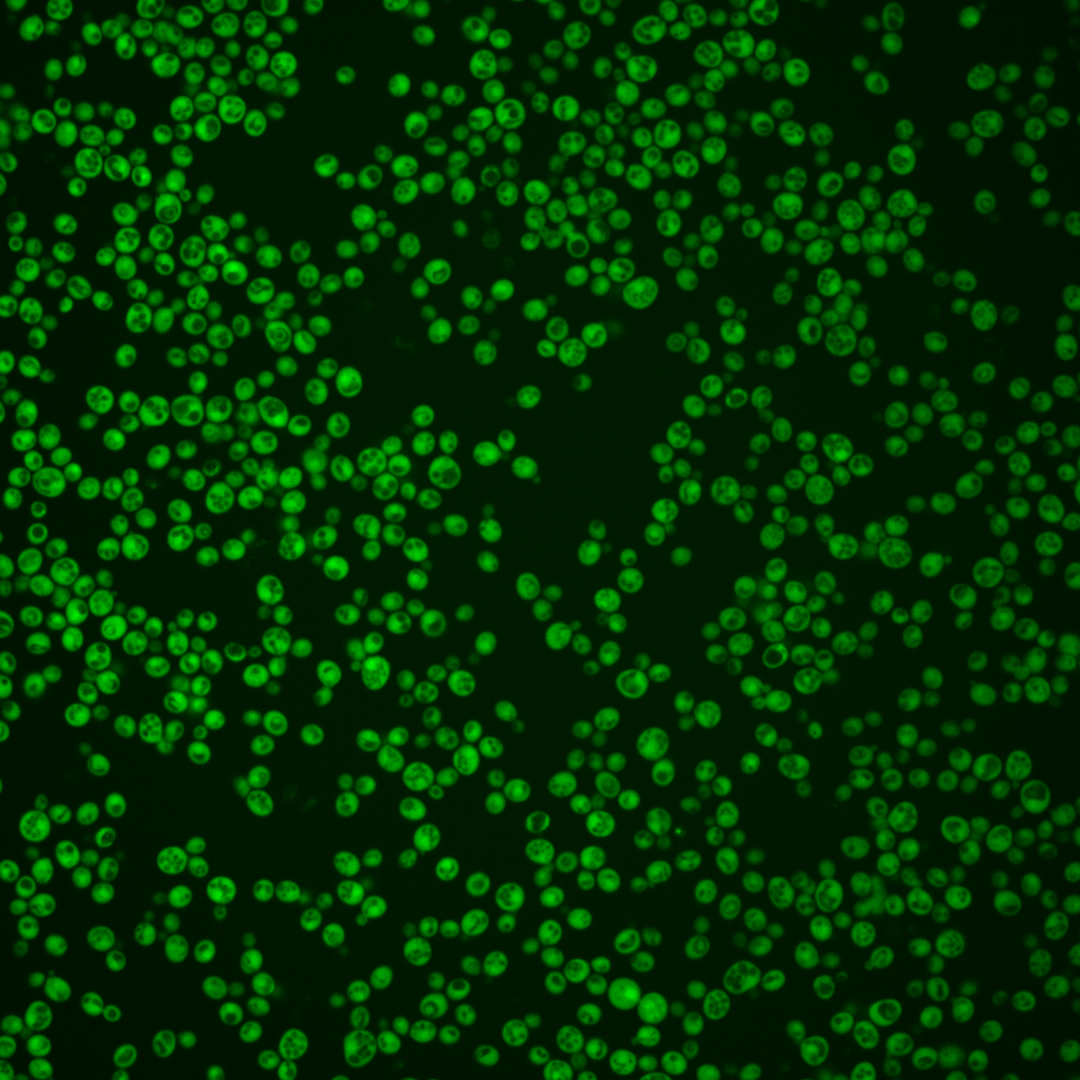

| Standard name | |
|---|---|
| Human Ortholog | |
| Description | Cytosine deaminase; zinc metalloenzyme that catalyzes the hydrolytic deamination of cytosine to uracil; of biomedical interest because it also catalyzes the deamination of 5-fluorocytosine (5FC) to form anticancer drug 5-fluorouracil (5FU) |
Micrographs




















































































Sub-cellular Localization
Yeast GFP Assignment
Protein Abundance
Localization Change
External localization resources
| ensLOC | DeepLoc | |||||||||||||||||||||||
|---|---|---|---|---|---|---|---|---|---|---|---|---|---|---|---|---|---|---|---|---|---|---|---|---|
| Localization | WT1 | WT2 | WT3 | RAP60 | RAP140 | RAP220 | RAP300 | RAP380 | RAP460 | RAP540 | RAP620 | RAP700 | HU80 | HU120 | HU160 | rpd3Δ_1 | rpd3Δ_2 | rpd3Δ_3 | WT1 | WT2 | WT3 | AF100 | AF140 | AF180 |
| Cortical Patches | 0 | 0 | 0 | 0 | 0 | 2 | – | 0 | 1 | 0 | 0 | 0 | 0 | 0 | 1 | 0 | 0 | 0 | 0 | 0 | 0 | 0 | 0 | 2 |
| Bud | 1 | 0 | 1 | 0 | 0 | 0 | – | 2 | 0 | 1 | 0 | 3 | 0 | 0 | 1 | 0 | 0 | 0 | 2 | 0 | 0 | 1 | 2 | 0 |
| Bud Neck | 0 | 0 | 0 | 0 | 0 | 0 | – | 0 | 0 | 0 | 0 | 0 | 0 | 0 | 0 | 0 | 0 | 0 | 0 | 0 | 0 | 0 | 0 | 0 |
| Bud Site | 0 | 0 | 0 | 0 | 0 | 0 | – | 0 | 0 | 0 | 0 | 0 | 0 | 0 | 0 | 0 | 0 | 0 | – | – | – | – | – | – |
| Cell Periphery | 3 | 1 | 2 | 1 | 3 | 3 | – | 6 | 13 | 7 | 9 | 11 | 0 | 1 | 3 | 0 | 0 | 0 | 0 | 0 | 0 | 0 | 0 | 0 |
| Cytoplasm | 529 | 174 | 305 | 179 | 287 | 368 | – | 264 | 266 | 224 | 217 | 216 | 509 | 642 | 597 | 78 | 105 | 59 | 502 | 167 | 287 | 403 | 460 | 483 |
| Endoplasmic Reticulum | 1 | 0 | 0 | 0 | 5 | 3 | – | 10 | 12 | 15 | 3 | 7 | 1 | 5 | 2 | 0 | 0 | 0 | 1 | 0 | 0 | 3 | 2 | 5 |
| Endosome | 0 | 0 | 0 | 0 | 0 | 0 | – | 0 | 0 | 2 | 0 | 0 | 0 | 1 | 0 | 0 | 0 | 0 | 0 | 0 | 0 | 0 | 1 | 3 |
| Golgi | 0 | 0 | 0 | 0 | 0 | 0 | – | 2 | 1 | 0 | 0 | 0 | 1 | 3 | 2 | 0 | 0 | 0 | 0 | 0 | 0 | 0 | 2 | 4 |
| Mitochondria | 1 | 1 | 0 | 3 | 1 | 18 | – | 7 | 50 | 71 | 71 | 93 | 2 | 0 | 0 | 0 | 1 | 1 | 0 | 0 | 0 | 1 | 1 | 1 |
| Nucleus | 4 | 3 | 4 | 1 | 0 | 1 | – | 7 | 4 | 3 | 5 | 9 | 0 | 1 | 0 | 3 | 0 | 1 | 2 | 2 | 3 | 3 | 5 | 3 |
| Nuclear Periphery | 0 | 0 | 1 | 0 | 0 | 0 | – | 2 | 2 | 2 | 2 | 1 | 0 | 0 | 0 | 0 | 0 | 0 | 0 | 0 | 0 | 0 | 2 | 1 |
| Nucleolus | 0 | 0 | 0 | 0 | 0 | 1 | – | 1 | 0 | 0 | 0 | 0 | 0 | 0 | 1 | 0 | 0 | 0 | 0 | 0 | 0 | 0 | 0 | 0 |
| Peroxisomes | 0 | 0 | 0 | 0 | 0 | 0 | – | 0 | 0 | 0 | 0 | 0 | 0 | 0 | 0 | 0 | 0 | 0 | 0 | 0 | 0 | 0 | 0 | 0 |
| SpindlePole | 0 | 0 | 0 | 0 | 0 | 0 | – | 0 | 1 | 0 | 0 | 0 | 0 | 0 | 1 | 0 | 0 | 0 | 0 | 0 | 0 | 0 | 0 | 0 |
| Vac/Vac Membrane | 3 | 0 | 3 | 3 | 8 | 10 | – | 70 | 37 | 42 | 15 | 35 | 10 | 2 | 3 | 5 | 7 | 6 | 3 | 1 | 1 | 3 | 4 | 3 |
| Unique Cell Count | 533 | 176 | 310 | 186 | 300 | 394 | 357 | 353 | 340 | 303 | 345 | 519 | 650 | 605 | 83 | 113 | 65 | 518 | 175 | 302 | 422 | 486 | 516 | |
| Labelled Cell Count | 542 | 179 | 316 | 187 | 304 | 406 | 371 | 387 | 367 | 322 | 375 | 523 | 655 | 611 | 86 | 113 | 67 | 518 | 175 | 302 | 422 | 486 | 516 | |
Yeast GFP Assignment
Protein Abundance
| Screen | WT1 | WT2 | WT3 | RAP60 | RAP140 | RAP220 | RAP300 | RAP380 | RAP460 | RAP540 | RAP620 | RAP700 | HU80 | HU120 | HU160 | rpd3Δ_1 | rpd3Δ_2 | rpd3Δ_3 | AF100 | AF140 | AF180 |
|---|---|---|---|---|---|---|---|---|---|---|---|---|---|---|---|---|---|---|---|---|---|
| Mean Cell GFP Intensity (1e-4) | 20.2 | 25.2 | 13.8 | 18.7 | 18.2 | 14.8 | – | 12.0 | 10.6 | 10.0 | 9.6 | 9.1 | 22.6 | 22.5 | 21.0 | 31.4 | 27.0 | 31.7 | 20.8 | 21.1 | 20.9 |
| Std Deviation (1e-4) | 3.9 | 4.5 | 3.0 | 4.1 | 3.5 | 3.1 | – | 2.6 | 2.3 | 2.0 | 2.1 | 1.7 | 4.4 | 3.8 | 3.7 | 11.5 | 11.3 | 11.9 | 3.8 | 4.6 | 4.4 |
| Intensity Change (Log2) | – | – | – | 0.43 | 0.4 | 0.1 | – | -0.21 | -0.38 | -0.46 | -0.53 | -0.6 | 0.71 | 0.7 | 0.6 | 1.18 | 0.96 | 1.2 | 0.59 | 0.61 | 0.6 |
Localization Change
| Localization | RAP60 | RAP140 | RAP220 | RAP300 | RAP380 | RAP460 | RAP540 | RAP620 | RAP700 | HU80 | HU120 | HU160 | rpd3Δ_1 | rpd3Δ_2 | rpd3Δ_3 |
|---|---|---|---|---|---|---|---|---|---|---|---|---|---|---|---|
| Cortical Patches | 0 | 0 | 0 | – | 0 | 0 | 0 | 0 | 0 | 0 | 0 | 0 | 0 | 0 | 0 |
| Bud | 0 | 0 | 0 | – | 0 | 0 | 0 | 0 | 0 | 0 | 0 | 0 | 0 | 0 | 0 |
| Bud Neck | 0 | 0 | 0 | – | 0 | 0 | 0 | 0 | 0 | 0 | 0 | 0 | 0 | 0 | 0 |
| Bud Site | 0 | 0 | 0 | – | 0 | 0 | 0 | 0 | 0 | 0 | 0 | 0 | 0 | 0 | 0 |
| Cell Periphery | 0 | 0 | 0 | – | 0 | 2.6 | 0 | 2.2 | 2.3 | 0 | 0 | 0 | 0 | 0 | 0 |
| Cytoplasm | -1.5 | -2.0 | -3.2 | – | -8.9 | -8.6 | -10.6 | -9.3 | -11.3 | -0.3 | 0.5 | 0.4 | -2.3 | -2.9 | -3.3 |
| Endoplasmic Reticulum | 0 | 0 | 0 | – | 0 | 3.3 | 3.7 | 0 | 0 | 0 | 0 | 0 | 0 | 0 | 0 |
| Endosome | 0 | 0 | 0 | – | 0 | 0 | 0 | 0 | 0 | 0 | 0 | 0 | 0 | 0 | 0 |
| Golgi | 0 | 0 | 0 | – | 0 | 0 | 0 | 0 | 0 | 0 | 0 | 0 | 0 | 0 | 0 |
| Mitochondria | 0 | 0 | 3.8 | – | 0 | 6.9 | 8.5 | 9.1 | 9.9 | 0 | 0 | 0 | 0 | 0 | 0 |
| Nucleus | 0 | 0 | 0 | – | 0.7 | 0 | 0 | 0 | 1.2 | 0 | 0 | 0 | 0 | 0 | 0 |
| Nuclear Periphery | 0 | 0 | 0 | – | 0 | 0 | 0 | 0 | 0 | 0 | 0 | 0 | 0 | 0 | 0 |
| Nucleolus | 0 | 0 | 0 | – | 0 | 0 | 0 | 0 | 0 | 0 | 0 | 0 | 0 | 0 | 0 |
| Peroxisomes | 0 | 0 | 0 | – | 0 | 0 | 0 | 0 | 0 | 0 | 0 | 0 | 0 | 0 | 0 |
| SpindlePole | 0 | 0 | 0 | – | 0 | 0 | 0 | 0 | 0 | 0 | 0 | 0 | 0 | 0 | 0 |
| Vacuole | 0 | 1.6 | 1.5 | – | 7.7 | 5.1 | 5.7 | 2.9 | 5.0 | 0 | 0 | 0 | 0 | 0 | 0 |
External localization resources
Images






























Protein Concentration and Protein Localization Data
| R1 | R2 | R3 | ||||||||||||||||
|---|---|---|---|---|---|---|---|---|---|---|---|---|---|---|---|---|---|---|
| G1 Pre-START | G1 Post-START | S/G2 | Metaphase | Anaphase | Telophase | G1 Pre-START | G1 Post-START | S/G2 | Metaphase | Anaphase | Telophase | G1 Pre-START | G1 Post-START | S/G2 | Metaphase | Anaphase | Telophase | |
| Concentration | 19.1617 | 23.7114 | 20.8871 | 22.5672 | 19.3339 | 21.3043 | 16.9074 | 23.8615 | 19.6186 | 18.8105 | 18.3861 | 21.3934 | 20.7381 | 24.0108 | 22.9516 | 20.9863 | 15.4433 | 21.7191 |
| Actin | 0.0129 | 0.0001 | 0.0146 | 0.0008 | 0.0005 | 0.005 | 0.0168 | 0.0009 | 0.0168 | 0.0168 | 0.0015 | 0.0002 | 0.0102 | 0.0003 | 0.0001 | 0.0571 | 0.006 | 0.0002 |
| Bud | 0.0004 | 0 | 0.0003 | 0.0002 | 0.0001 | 0.0003 | 0.0012 | 0.0001 | 0.0011 | 0.0007 | 0.0001 | 0.0002 | 0.0002 | 0.0001 | 0.0001 | 0.0002 | 0.0017 | 0.0001 |
| Bud Neck | 0.0003 | 0.0001 | 0.0007 | 0.0005 | 0.0003 | 0.0009 | 0.0008 | 0.0001 | 0.0006 | 0.0006 | 0.0004 | 0.0006 | 0.0004 | 0.0001 | 0.0002 | 0.0004 | 0.0008 | 0.0008 |
| Bud Periphery | 0.0002 | 0 | 0.0002 | 0.0004 | 0.0001 | 0.0002 | 0.0011 | 0 | 0.0007 | 0.0015 | 0 | 0.0001 | 0.0001 | 0.0001 | 0 | 0.0002 | 0.0013 | 0 |
| Bud Site | 0.0029 | 0 | 0.0024 | 0.0007 | 0.0002 | 0.0002 | 0.0022 | 0.0001 | 0.003 | 0.0003 | 0.0001 | 0.0001 | 0.0005 | 0.0001 | 0 | 0.0003 | 0.0013 | 0 |
| Cell Periphery | 0.0001 | 0 | 0.0001 | 0.0002 | 0 | 0 | 0.0003 | 0 | 0.0002 | 0.0001 | 0 | 0 | 0 | 0 | 0 | 0 | 0.0002 | 0 |
| Cytoplasm | 0.8591 | 0.9905 | 0.9151 | 0.9242 | 0.8777 | 0.9137 | 0.8405 | 0.9885 | 0.878 | 0.7937 | 0.9022 | 0.949 | 0.9348 | 0.981 | 0.9778 | 0.8857 | 0.6725 | 0.9574 |
| Cytoplasmic Foci | 0.0179 | 0.0002 | 0.0087 | 0.002 | 0.0172 | 0.0109 | 0.0151 | 0.001 | 0.0199 | 0.0087 | 0.0141 | 0.005 | 0.0028 | 0.0005 | 0.0003 | 0.0009 | 0.0366 | 0.0007 |
| Eisosomes | 0.0001 | 0 | 0.0001 | 0 | 0 | 0 | 0.0001 | 0 | 0.0001 | 0.0001 | 0 | 0 | 0 | 0 | 0 | 0.0002 | 0.0001 | 0 |
| Endoplasmic Reticulum | 0.0037 | 0.0002 | 0.0014 | 0.0017 | 0.0014 | 0.0014 | 0.0091 | 0.0002 | 0.0071 | 0.0015 | 0.0019 | 0.0015 | 0.0027 | 0.0003 | 0.0003 | 0.0006 | 0.0133 | 0.001 |
| Endosome | 0.0309 | 0 | 0.0094 | 0.0134 | 0.0562 | 0.0129 | 0.0297 | 0.0001 | 0.0156 | 0.0241 | 0.0192 | 0.0047 | 0.0064 | 0.0009 | 0.0001 | 0.0015 | 0.043 | 0.0006 |
| Golgi | 0.011 | 0 | 0.0093 | 0.0021 | 0.0152 | 0.0075 | 0.0125 | 0 | 0.0055 | 0.0303 | 0.0283 | 0.0003 | 0.0029 | 0.0002 | 0 | 0.0029 | 0.0182 | 0 |
| Lipid Particles | 0.0047 | 0 | 0.0039 | 0.0089 | 0.002 | 0.0087 | 0.0066 | 0 | 0.0066 | 0.0009 | 0.0031 | 0.0005 | 0.001 | 0.0005 | 0 | 0.0011 | 0.0435 | 0 |
| Mitochondria | 0.0051 | 0 | 0.0035 | 0.0104 | 0.0046 | 0.0043 | 0.0106 | 0.0001 | 0.0146 | 0.059 | 0.0013 | 0.0047 | 0.0003 | 0.0058 | 0.0001 | 0.0005 | 0.0409 | 0.0001 |
| None | 0.0057 | 0.0002 | 0.0006 | 0.0005 | 0.0004 | 0.0004 | 0.0018 | 0.0005 | 0.0047 | 0.0002 | 0.0002 | 0.001 | 0.0007 | 0.0003 | 0.0003 | 0.0004 | 0.0279 | 0.0003 |
| Nuclear Periphery | 0.0088 | 0.0007 | 0.0018 | 0.0059 | 0.0034 | 0.005 | 0.0114 | 0.0007 | 0.0048 | 0.0029 | 0.0054 | 0.0042 | 0.0038 | 0.0008 | 0.002 | 0.0055 | 0.028 | 0.0033 |
| Nucleolus | 0.0003 | 0 | 0.0004 | 0.001 | 0 | 0.0001 | 0.0002 | 0 | 0.0008 | 0 | 0 | 0.0001 | 0 | 0.0001 | 0 | 0 | 0.0018 | 0 |
| Nucleus | 0.0265 | 0.0076 | 0.0121 | 0.0137 | 0.0176 | 0.0249 | 0.0266 | 0.0072 | 0.0123 | 0.0535 | 0.0104 | 0.0226 | 0.0303 | 0.0073 | 0.0182 | 0.0409 | 0.0216 | 0.0345 |
| Peroxisomes | 0.0013 | 0 | 0.0128 | 0.0005 | 0.0006 | 0.0014 | 0.0027 | 0.0001 | 0.0039 | 0.0013 | 0.0023 | 0.0001 | 0.0012 | 0.0001 | 0 | 0.0008 | 0.0153 | 0 |
| Punctate Nuclear | 0.0054 | 0.0001 | 0.0008 | 0.0006 | 0.0006 | 0.0008 | 0.0022 | 0.0004 | 0.0013 | 0.0004 | 0.0003 | 0.0007 | 0.0006 | 0.0001 | 0.0003 | 0.0006 | 0.0163 | 0.0004 |
| Vacuole | 0.0015 | 0.0001 | 0.0015 | 0.008 | 0.0014 | 0.0008 | 0.0068 | 0.0001 | 0.0017 | 0.0012 | 0.0078 | 0.0029 | 0.0008 | 0.0006 | 0.0001 | 0.0002 | 0.0065 | 0.0005 |
| Vacuole Periphery | 0.0011 | 0 | 0.0003 | 0.0041 | 0.0006 | 0.0005 | 0.0017 | 0 | 0.0008 | 0.0019 | 0.0014 | 0.0014 | 0.0002 | 0.0006 | 0 | 0.0001 | 0.0031 | 0.0002 |
Sequencing Data
| R1 | R2 | |||||||||
|---|---|---|---|---|---|---|---|---|---|---|
| G1 Post-START | S/G2 | Metaphase | Anaphase | Telophase | G1 Post-START | S/G2 | Metaphase | Anaphase | Telophase | |
| Gene Expression | 75.1795 | 68.2399 | 122.7562 | 139.5526 | 136.463 | 110.9729 | 110.8138 | 136.8832 | 171.6319 | 120.2765 |
| Translational Efficiency | 4.8306 | 6.0205 | 2.8395 | 2.4552 | 2.892 | 3.4755 | 3.4344 | 2.4894 | 2.0127 | 2.6793 |
Hit Data
| Dataset | Hit |
|---|---|
| Protein Concentration | ✘ |
| Protein Localization | ✘ |
| Gene Expression | ✘ |
| Translational Efficiency | ✘ |
Micrographs
































Cell Count
| R1 | R2 | R1 & R2 | |||||||||
|---|---|---|---|---|---|---|---|---|---|---|---|
| WT | UBP2 | UBP14 | UBP2UBP14 | WT | UBP2 | UBP14 | UBP2UBP14 | WT | UBP2 | UBP14 | UBP2UBP14 |
| 2397 | 4 | 1200 | 1185 | 1752 | 1 | 1828 | 1617 | 4149 | 5 | 3028 | 2802 |
Protein Abundance
| R1 | R2 | R1 & R2 | ||||||||||
|---|---|---|---|---|---|---|---|---|---|---|---|---|
| WT | UBP2 | UBP14 | UBP2UBP14 | WT | UBP2 | UBP14 | UBP2UBP14 | WT | UBP2 | UBP14 | UBP2UBP14 | |
| Mean | 1208.76 | 1582.62 | 2125.04 | 2096.49 | 1309.67 | 1615.78 | 2174.54 | 2145.04 | 1251.37 | 1589.25 | 2154.92 | 2124.51 |
| Standard Deviation | 190.15 | 192.58 | 321.14 | 373.33 | 234.51 | — | 316.20 | 386.49 | 215.86 | 172.76 | 319.09 | 381.74 |
| Intensity Change Log 2 | — | 0.388787 | 0.813962 | 0.794448 | — | 0.303027 | 0.731507 | 0.711801 | — | 0.344826 | 0.771671 | 0.752060 |
Localization Score (DeepLoc)
| R1 | R2 | R1 & R2 | ||||||||||
|---|---|---|---|---|---|---|---|---|---|---|---|---|
| WT | UBP2 | UBP14 | UBP2UBP14 | WT | UBP2 | UBP14 | UBP2UBP14 | WT | UBP2 | UBP14 | UBP2UBP14 | |
| Actin | 0.000051 | 0.000446 | 0.000141 | 0.001088 | 0.000084 | 0.000020 | 0.000340 | 0.000682 | 0.000065 | 0.000361 | 0.000261 | 0.000854 |
| Bud Neck | 0.000306 | 0.000959 | 0.001133 | 0.004031 | 0.000217 | 0.000061 | 0.001232 | 0.003139 | 0.000269 | 0.000779 | 0.001193 | 0.003516 |
| Bud Site | 0.001048 | 0.053951 | 0.001132 | 0.015948 | 0.001101 | 0.000383 | 0.002581 | 0.010128 | 0.001070 | 0.043238 | 0.002007 | 0.012589 |
| Cell Periphery | 0.000024 | 0.004318 | 0.000137 | 0.000343 | 0.000031 | 0.000014 | 0.000104 | 0.000146 | 0.000027 | 0.003457 | 0.000117 | 0.000229 |
| Cytoplasm | 0.860716* | 0.923408* | 0.554698* | 0.661433* | 0.866242* | 0.937909* | 0.642181* | 0.644054* | 0.863049* | 0.926308* | 0.607512* | 0.651404* |
| Cytoplasmic Foci | 0.013764 | 0.001399 | 0.003637 | 0.006151 | 0.009413 | 0.001770 | 0.003137 | 0.010443 | 0.011927 | 0.001474 | 0.003335 | 0.008628 |
| Eisosomes | 0.000002 | 0.000011 | 0.000001 | 0.000006 | 0.000001 | 0.000001 | 0.000001 | 0.000005 | 0.000002 | 0.000009 | 0.000001 | 0.000005 |
| Endoplasmic Reticulum | 0.000204 | 0.000056 | 0.000094 | 0.000746 | 0.000305 | 0.000023 | 0.000068 | 0.000284 | 0.000246 | 0.000049 | 0.000079 | 0.000479 |
| Endosome | 0.000273 | 0.000108 | 0.000095 | 0.002101 | 0.000240 | 0.000055 | 0.000109 | 0.005560 | 0.000259 | 0.000098 | 0.000104 | 0.004098 |
| Golgi | 0.000201 | 0.000106 | 0.000205 | 0.007760 | 0.000353 | 0.000062 | 0.000165 | 0.014035 | 0.000265 | 0.000097 | 0.000181 | 0.011381 |
| Lipid Particles | 0.000111 | 0.000508 | 0.000262 | 0.001655 | 0.000155 | 0.000010 | 0.000361 | 0.001076 | 0.000129 | 0.000408 | 0.000322 | 0.001321 |
| Mitochondria | 0.000126 | 0.000033 | 0.000256 | 0.001786 | 0.000463 | 0.000006 | 0.000193 | 0.001537 | 0.000268 | 0.000027 | 0.000218 | 0.001642 |
| Mitotic Spindle | 0.000817 | 0.000230 | 0.001692 | 0.019438 | 0.000665 | 0.000030 | 0.006026 | 0.080394 | 0.000753 | 0.000190 | 0.004308 | 0.054615 |
| None | 0.012695 | 0.000810 | 0.012615 | 0.008272 | 0.006195 | 0.011112 | 0.014319 | 0.008902 | 0.009950 | 0.002870 | 0.013644 | 0.008636 |
| Nuclear Periphery | 0.000062 | 0.000016 | 0.000218 | 0.000229 | 0.000068 | 0.000024 | 0.000193 | 0.000419 | 0.000065 | 0.000018 | 0.000203 | 0.000338 |
| Nuclear Periphery Foci | 0.001281 | 0.000442 | 0.000666 | 0.002903 | 0.001680 | 0.003758 | 0.000774 | 0.004475 | 0.001450 | 0.001105 | 0.000731 | 0.003810 |
| Nucleolus | 0.000165 | 0.000041 | 0.000093 | 0.000194 | 0.000108 | 0.000072 | 0.000095 | 0.001761 | 0.000141 | 0.000047 | 0.000095 | 0.001098 |
| Nucleus | 0.098889 | 0.006508 | 0.418213* | 0.235950* | 0.102705 | 0.043298 | 0.320459* | 0.179476* | 0.100500 | 0.013866 | 0.359199* | 0.203359* |
| Peroxisomes | 0.000060 | 0.000102 | 0.000029 | 0.000326 | 0.000032 | 0.000004 | 0.000075 | 0.000241 | 0.000048 | 0.000082 | 0.000056 | 0.000277 |
| Vacuole | 0.009114 | 0.006443 | 0.004637 | 0.023729 | 0.009058 | 0.001377 | 0.007551 | 0.024834 | 0.009090 | 0.005430 | 0.006396 | 0.024367 |
| Vacuole Periphery | 0.000093 | 0.000106 | 0.000046 | 0.005913 | 0.000887 | 0.000012 | 0.000034 | 0.008411 | 0.000428 | 0.000087 | 0.000039 | 0.007354 |
Localization Changes (T-score)
| R1 | R2 | R1 & R2 | |||||||||||||
|---|---|---|---|---|---|---|---|---|---|---|---|---|---|---|---|
| UBP2_WT | UBP14_WT | UBP2UBP14_WT | UBP2UBP14_UBP2 | UBP2UBP14_UBP14 | UBP2_WT | UBP14_WT | UBP2UBP14_WT | UBP2UBP14_UBP2 | UBP2UBP14_UBP14 | UBP2_WT | UBP14_WT | UBP2UBP14_WT | UBP2UBP14_UBP2 | UBP2UBP14_UBP14 | |
| Actin | NaN | NaN | NaN | NaN | NaN | NaN | NaN | NaN | NaN | NaN | NaN | NaN | NaN | NaN | NaN |
| Bud Neck | NaN | NaN | NaN | NaN | NaN | NaN | NaN | NaN | NaN | NaN | NaN | NaN | NaN | NaN | NaN |
| Bud Site | NaN | NaN | NaN | NaN | NaN | NaN | NaN | NaN | NaN | NaN | NaN | NaN | NaN | NaN | NaN |
| Cell Periphery | NaN | NaN | NaN | NaN | NaN | NaN | NaN | NaN | NaN | NaN | NaN | NaN | NaN | NaN | NaN |
| Cytoplasm | NaN | NaN | NaN | NaN | NaN | NaN | NaN | NaN | NaN | NaN | NaN | NaN | NaN | NaN | NaN |
| Cytoplasmic Foci | NaN | NaN | NaN | NaN | NaN | NaN | NaN | NaN | NaN | NaN | NaN | NaN | NaN | NaN | NaN |
| Eisosomes | NaN | NaN | NaN | NaN | NaN | NaN | NaN | NaN | NaN | NaN | NaN | NaN | NaN | NaN | NaN |
| Endoplasmic Reticulum | NaN | NaN | NaN | NaN | NaN | NaN | NaN | NaN | NaN | NaN | NaN | NaN | NaN | NaN | NaN |
| Endosome | NaN | NaN | NaN | NaN | NaN | NaN | NaN | NaN | NaN | NaN | NaN | NaN | NaN | NaN | NaN |
| Golgi | NaN | NaN | NaN | NaN | NaN | NaN | NaN | NaN | NaN | NaN | NaN | NaN | NaN | NaN | NaN |
| Lipid Particles | NaN | NaN | NaN | NaN | NaN | NaN | NaN | NaN | NaN | NaN | NaN | NaN | NaN | NaN | NaN |
| Mitochondria | NaN | NaN | NaN | NaN | NaN | NaN | NaN | NaN | NaN | NaN | NaN | NaN | NaN | NaN | NaN |
| Mitotic Spindle | NaN | NaN | NaN | NaN | NaN | NaN | NaN | NaN | NaN | NaN | NaN | NaN | NaN | NaN | NaN |
| None | NaN | NaN | NaN | NaN | NaN | NaN | NaN | NaN | NaN | NaN | NaN | NaN | NaN | NaN | NaN |
| Nuclear Periphery | NaN | NaN | NaN | NaN | NaN | NaN | NaN | NaN | NaN | NaN | NaN | NaN | NaN | NaN | NaN |
| Nuclear Periphery Foci | NaN | NaN | NaN | NaN | NaN | NaN | NaN | NaN | NaN | NaN | NaN | NaN | NaN | NaN | NaN |
| Nucleolus | NaN | NaN | NaN | NaN | NaN | NaN | NaN | NaN | NaN | NaN | NaN | NaN | NaN | NaN | NaN |
| Nucleus | NaN | NaN | NaN | NaN | NaN | NaN | NaN | NaN | NaN | NaN | NaN | NaN | NaN | NaN | NaN |
| Peroxisomes | NaN | NaN | NaN | NaN | NaN | NaN | NaN | NaN | NaN | NaN | NaN | NaN | NaN | NaN | NaN |
| Vacuole | NaN | NaN | NaN | NaN | NaN | NaN | NaN | NaN | NaN | NaN | NaN | NaN | NaN | NaN | NaN |
| Vacuole Periphery | NaN | NaN | NaN | NaN | NaN | NaN | NaN | NaN | NaN | NaN | NaN | NaN | NaN | NaN | NaN |
Endocytosis
| Temp | Actin Patch (Sac6-tdTomato) | Cortical Patch (Sla1-GFP) | Late Endosome (Snf7-GFP) | Vacuole (Vph1-GFP) |
|---|---|---|---|---|
| 37℃ | ||||
| RT |
Cell Cycle Omics
CYCLoPs (Fcy1-GFP)
| Gene / Allele | Actin Patch (Sac6-tdTomato) | Cortical Patch (Sla1-GFP) | Late Endosome (Snf7-GFP) | Vacuole (Sac6-tdTomato) |
|---|
| Gene | Images |
|---|
| Gene | Images |
|---|
Images are not yet available
Images are not yet available